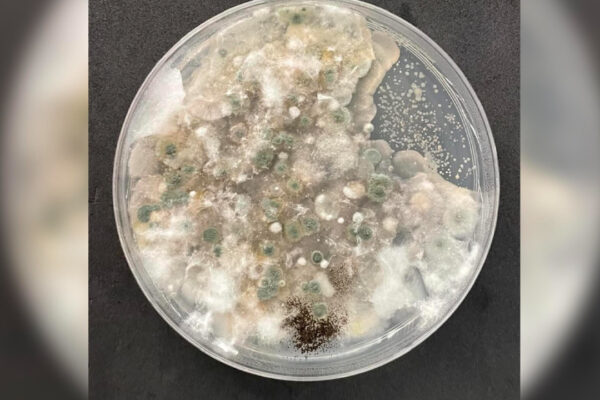

El investigador Billy Peralta habla del trabajo que está realizando en torno a los sismos y explica el uso que se está haciendo para adelantarse a emergencias del clima. Leer Más
Categoría / Ciencia
La nueva autoridad es Licenciada en Ciencias con mención en Química de la Universidad de Chile, donde también obtuvo su doctorado en Química. Leer Más